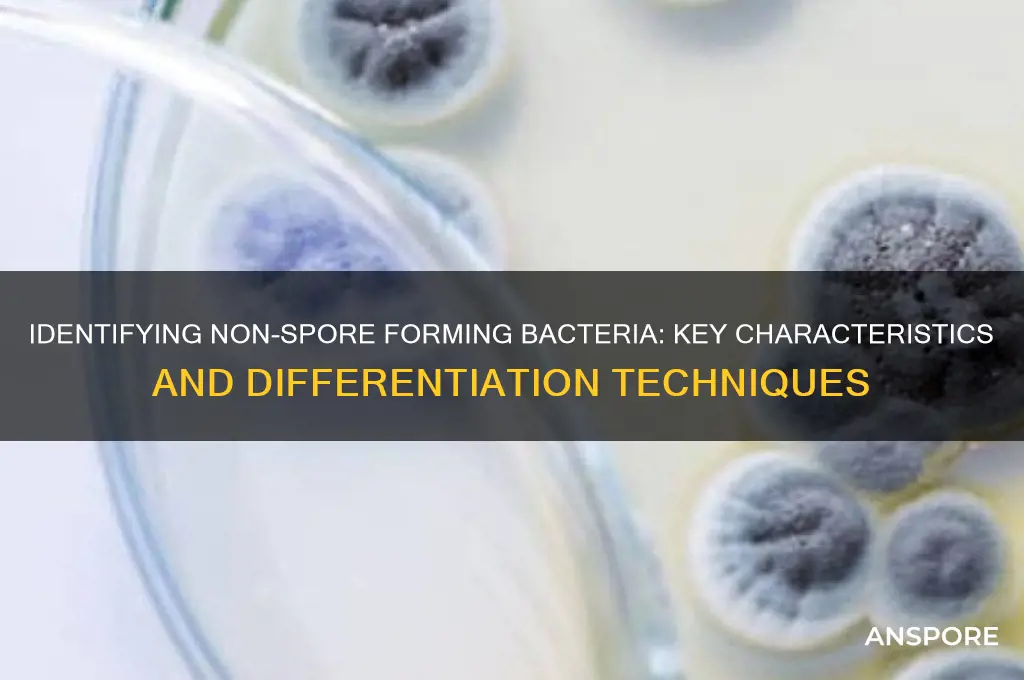
how to differentiate non spore forming bacteria

Differentiating non-spore-forming bacteria is a critical skill in microbiology, as it allows for accurate identification and targeted treatment of infections. Unlike spore-forming bacteria, which can survive harsh conditions by forming dormant spores, non-spore-forming bacteria lack this protective mechanism, making them more susceptible to environmental stresses. To differentiate these organisms, microbiologists employ various methods, including Gram staining to classify them as Gram-positive or Gram-negative, biochemical tests to assess metabolic activities, and molecular techniques like PCR for precise identification. Additionally, observing colony morphology, growth patterns, and antibiotic susceptibility profiles aids in distinguishing between different species. Understanding these characteristics is essential for clinical diagnostics, food safety, and environmental monitoring, ensuring effective management of bacterial infections and contamination.
| Characteristics | Values |
|---|---|
| Spore Formation | Absent |
| Gram Stain | Can be either Gram-positive or Gram-negative |
| Cell Wall Composition | Peptidoglycan present, but lacks the thick, multi-layered structure of spore-forming bacteria |
| Resistance to Heat and Desiccation | Low; non-spore formers are generally more susceptible to heat, drying, and disinfectants |
| Metabolism | Diverse metabolic capabilities, often requiring specific nutrients and conditions for growth |
| Growth Requirements | Typically require richer media and more controlled environments compared to spore-forming bacteria |
| Examples | Escherichia coli, Staphylococcus aureus, Streptococcus pneumoniae, Pseudomonas aeruginosa |
| Pathogenicity | Many are pathogens, but not all; depends on the species |
| Antibiotic Susceptibility | Generally more susceptible to antibiotics compared to spore-forming bacteria, though resistance can develop |
| Morphology | Vary in shape (cocci, bacilli, spirilla) but lack the distinct spore structures |
| Reproduction | Primarily by binary fission, no specialized reproductive structures like spores |
| Environmental Survival | Less capable of surviving harsh conditions without protection |
| Laboratory Identification | Identified through biochemical tests, molecular methods, and absence of spore staining (e.g., Schaeffer-Fulton stain) |
| Clinical Significance | Often associated with acute infections rather than long-term environmental persistence |
Explore related products
What You'll Learn
- Gram Staining Technique: Differentiates bacteria based on cell wall composition using stains
- Metabolic Tests: Identifies bacteria by their ability to use specific nutrients
- Morphological Characteristics: Examines shape, arrangement, and size under a microscope
- Biochemical Tests: Uses enzyme activity and chemical reactions for identification
- Antibiotic Susceptibility: Tests response to antibiotics to classify bacterial types

Gram Staining Technique: Differentiates bacteria based on cell wall composition using stains
The Gram staining technique is a cornerstone in microbiology, offering a rapid and reliable method to differentiate bacteria based on their cell wall composition. By categorizing bacteria into Gram-positive and Gram-negative groups, this technique provides critical insights into their structure, behavior, and susceptibility to antibiotics. The process hinges on the differential retention of stains due to variations in the thickness of the peptidoglycan layer and the presence or absence of an outer lipid membrane.
Steps to Perform Gram Staining:
- Preparation: Heat-fix a bacterial smear on a glass slide to adhere cells firmly.
- Primary Stain: Apply crystal violet for 1 minute, allowing it to penetrate all cells.
- Mordant: Add Gram’s iodine for 1 minute to form a complex with the crystal violet, trapping it within the cell.
- Decolorization: Wash the slide with 95% ethanol for 10–20 seconds. Gram-positive bacteria retain the stain due to their thick peptidoglycan layer, while Gram-negative bacteria lose it as their thin peptidoglycan and outer membrane are disrupted.
- Counterstain: Apply safranin for 45 seconds to stain decolorized Gram-negative bacteria pink.
- Observation: Examine under a microscope. Gram-positive bacteria appear purple, while Gram-negative bacteria appear pink.
Cautions and Practical Tips:
- Avoid over-decolorizing, as it can lead to false-negative results for Gram-positive bacteria.
- Ensure the smear is thin and even to prevent overlapping cells, which can obscure results.
- Use a timer to maintain consistency in staining and decolorization times.
Analytical Insight:
The Gram stain’s simplicity belies its significance. For non-spore-forming bacteria, this technique is particularly valuable as it quickly narrows down identification possibilities. For instance, *Staphylococcus aureus* (Gram-positive) and *Escherichia coli* (Gram-negative) can be distinguished within minutes, guiding initial treatment decisions in clinical settings.
Takeaway:
Mastering the Gram staining technique is essential for anyone working in microbiology or clinical diagnostics. Its ability to differentiate bacteria based on cell wall composition not only aids in identification but also informs antibiotic selection, making it an indispensable tool in the fight against bacterial infections.
Wilted Mushrooms: Can You Still Obtain Spore Prints Effectively?
You may want to see also

Metabolic Tests: Identifies bacteria by their ability to use specific nutrients
Bacteria, though microscopic, exhibit a remarkable diversity in their metabolic capabilities, which can be harnessed to differentiate between species, particularly non-spore forming ones. Metabolic tests leverage this diversity by observing how bacteria utilize specific nutrients, producing distinct biochemical signatures that serve as identifiers. For instance, the ability to ferment glucose or lactose can distinguish between *Escherichia coli* and *Salmonella*, as the former typically ferments both, while the latter often does not ferment lactose. These tests are not just theoretical tools; they are practical, cost-effective methods widely used in clinical and environmental microbiology labs.
To perform metabolic tests, specific media are inoculated with the bacterial sample, often in the form of agar plates or broth tubes supplemented with particular nutrients and indicators. For example, MacConkey agar contains lactose and a pH indicator that changes color when lactose is fermented, allowing for the differentiation of lactose-fermenting bacteria like *E. coli* from non-fermenters like *Pseudomonas*. Another example is the Methyl Red (MR) test, which detects acid production from glucose metabolism. A positive MR test, indicated by a red color change, suggests mixed acid fermentation, characteristic of *E. coli*. Precision in inoculation and incubation conditions (e.g., 37°C for 24–48 hours) is critical, as deviations can lead to false results.
While metabolic tests are powerful, they are not without limitations. Some bacteria may exhibit variable results due to strain differences or environmental factors. For instance, certain strains of *Klebsiella* may show delayed lactose fermentation, complicating identification. Additionally, reliance on a single test can be misleading; a battery of tests, such as the Triple Sugar Iron (TSI) agar test, which assesses glucose and lactose fermentation along with hydrogen sulfide production, provides a more comprehensive profile. Cross-referencing results with other biochemical tests, like oxidase or catalase tests, enhances accuracy and reduces ambiguity.
In practical applications, metabolic tests are invaluable for diagnosing infections and monitoring food safety. For example, in a clinical setting, identifying *Staphylococcus aureus* (a non-spore forming pathogen) involves testing for coagulase activity and mannitol fermentation on mannitol salt agar. In food microbiology, detecting *Listeria monocytogenes* relies on its ability to grow at refrigeration temperatures (4°C) and ferment specific sugars like D-xylose. These tests not only aid in species identification but also provide insights into bacterial virulence and environmental adaptability, making them indispensable tools in both research and industry.
To maximize the utility of metabolic tests, standardization and interpretation guidelines are essential. Commercial kits like API strips (Analytical Profile Index) simplify the process by providing pre-prepared panels of metabolic tests, reducing human error and increasing reproducibility. However, interpreting results requires training and familiarity with bacterial metabolism. For instance, understanding that *Enterobacter* species typically produce gas from glucose fermentation on TSI agar can prevent misidentification as *Salmonella*. By combining metabolic tests with other methods, such as molecular techniques, microbiologists can achieve robust and reliable bacterial differentiation, even among closely related non-spore forming species.
Can Fungal Spores Duplicate? Unveiling the Science Behind Fungal Reproduction
You may want to see also

Morphological Characteristics: Examines shape, arrangement, and size under a microscope
Under a microscope, the shape of non-spore forming bacteria provides a critical first clue to their identity. Coccus, bacillus, and spirillum are the three primary morphologies, each pointing to distinct bacterial groups. Cocci appear spherical, often arranging in chains (streptococci), clusters (staphylococci), or pairs (diplococci). Bacilli, rod-shaped bacteria, may occur singly or in chains. Spirilla, with their corkscrew-like structure, are less common but unmistakable. Recognizing these shapes narrows the possibilities significantly, guiding further tests for precise identification.
Arrangement patterns offer additional discriminatory power. For instance, staphylococci’s grape-like clusters contrast sharply with streptococci’s linear chains, despite both being cocci. Similarly, bacilli may form long chains (e.g., *Bacillus anthracis*) or remain single (e.g., *Escherichia coli*). Some bacteria, like *Actinomyces*, exhibit filamentous arrangements, resembling fungal hyphae but lacking spores. Observing these patterns requires a 100x oil immersion objective for clarity, as arrangements can be subtle and easily missed at lower magnifications.
Size, though less definitive than shape or arrangement, still contributes to differentiation. Non-spore forming bacteria typically range from 0.5 to 5 micrometers in length, with cocci averaging 0.5–2 micrometers in diameter and bacilli 1–5 micrometers long. For example, *Mycoplasma*, the smallest non-spore forming bacteria, lack a cell wall and measure just 0.2–0.3 micrometers, making them invisible under a standard light microscope without special staining techniques like Giemsa or Gram. Calibrated micrometer scales can aid in precise measurements, enhancing accuracy.
Practical tips for morphological examination include preparing a wet mount with a thin, even smear to avoid overcrowding, which obscures individual cells. Use a Gram stain to enhance contrast and reveal cell wall characteristics, further aiding identification. For spirilla, phase-contrast microscopy highlights their helical shape without staining. Always compare observations to reference images or databases, as slight variations in shape or arrangement can distinguish between closely related species. Mastery of these techniques transforms morphology from a basic observation into a powerful diagnostic tool.
Are Psychoactive Spores Legal for Sale? Exploring the Legal Landscape
You may want to see also
Explore related products

Biochemical Tests: Uses enzyme activity and chemical reactions for identification
Biochemical tests are a cornerstone in differentiating non-spore-forming bacteria, leveraging the unique metabolic capabilities of these microorganisms. By detecting specific enzyme activities and chemical reactions, these tests reveal distinct biochemical profiles that serve as fingerprints for identification. For instance, the catalase test identifies bacteria capable of producing the enzyme catalase, which breaks down hydrogen peroxide into oxygen and water. A vigorous bubbling reaction indicates a catalase-positive organism, such as *Staphylococcus*, while its absence suggests *Streptococcus*. This simple yet powerful test highlights how enzyme activity can distinguish between closely related species.
To perform biochemical tests effectively, follow a systematic approach. Start by inoculating the bacteria into specific media or reagents designed to target particular metabolic pathways. For example, the methyl red (MR) test assesses the ability of bacteria to produce stable acidic byproducts through mixed acid fermentation. After incubating the culture with glucose and a pH indicator, a red color indicates acid production, characteristic of *Escherichia coli*. Conversely, a yellow color suggests a non-acidic fermenter like *Klebsiella*. Precision in inoculation volume (typically 0.5–1.0 mL) and incubation time (24–48 hours at 37°C) is critical for accurate results.
While biochemical tests are invaluable, they are not without limitations. False negatives or positives can occur due to factors like bacterial age, media composition, or reagent quality. For instance, older cultures may exhibit reduced enzyme activity, leading to misleading results. To mitigate this, use cultures in their logarithmic growth phase (18–24 hours old) and ensure reagents are fresh and properly stored. Additionally, some bacteria may exhibit atypical reactions, necessitating confirmatory tests. For example, *Enterobacter* and *Klebsiella* both produce gas in the triple sugar iron (TSI) agar test, but *Enterobacter* also produces a distinct alkaline slant, differentiating the two.
The practical utility of biochemical tests extends beyond laboratory identification. Clinically, they aid in diagnosing infections by pinpointing the causative pathogen, guiding targeted antibiotic therapy. For instance, the urease test identifies *Helicobacter pylori*, a urease-positive bacterium associated with gastric ulcers, by detecting ammonia production from urea. In industrial settings, these tests ensure product safety by identifying contaminants in food, pharmaceuticals, or water. By understanding the metabolic nuances of non-spore-forming bacteria, biochemical tests bridge the gap between microbiology theory and real-world applications, offering a reliable and cost-effective identification method.
Breloom's Spore Move: Learning Level and Battle Strategy Guide
You may want to see also

Antibiotic Susceptibility: Tests response to antibiotics to classify bacterial types
Antibiotic susceptibility testing is a cornerstone in differentiating non-spore-forming bacteria, offering critical insights into their classification and treatment. By exposing bacterial isolates to various antibiotics, clinicians can determine which drugs effectively inhibit growth, guiding targeted therapy. This method is particularly valuable for non-spore-forming bacteria, which often lack the resilience of their spore-forming counterparts, making them more susceptible to specific antibiotics. For instance, *Escherichia coli* and *Staphylococcus aureus*, both non-spore-forming, exhibit distinct susceptibility profiles, with *E. coli* often responding to beta-lactams like ampicillin, while *S. aureus* may require methicillin or vancomycin due to increasing resistance patterns.
The Kirby-Bauer disk diffusion test is a widely used method for antibiotic susceptibility testing. In this procedure, a standardized inoculum of the bacterial isolate is spread evenly on an agar plate, and antibiotic-impregnated disks are placed on the surface. After incubation (typically 18–24 hours at 35°C), the diameter of the inhibition zone around each disk is measured. For example, a zone size of ≥14 mm for ampicillin against *E. coli* typically indicates susceptibility, while ≤12 mm suggests resistance. However, interpretation must follow Clinical and Laboratory Standards Institute (CLSI) guidelines, as breakpoints vary by species and antibiotic.
Broth dilution methods, such as the MIC (Minimum Inhibitory Concentration) test, provide a more quantitative approach. Here, bacteria are exposed to serial dilutions of antibiotics in broth, and the lowest concentration that inhibits visible growth is recorded. For instance, an MIC of ≤8 μg/mL for ciprofloxacin against *Pseudomonas aeruginosa* indicates susceptibility, while ≥16 μg/mL suggests resistance. This method is particularly useful for fastidious non-spore-forming bacteria like *Streptococcus pneumoniae*, which may require precise antibiotic dosing to avoid treatment failure.
Automated systems, such as VITEK 2 or MicroScan, streamline susceptibility testing by combining inoculation, incubation, and result interpretation into a single platform. These systems are especially valuable in high-throughput clinical laboratories, reducing turnaround times from days to hours. For example, a VITEK 2 card can simultaneously test a *Klebsiella pneumoniae* isolate against 12–16 antibiotics, providing susceptibility results within 6–8 hours. However, these systems require careful validation and periodic quality control to ensure accuracy, as false results can lead to inappropriate treatment.
In practice, antibiotic susceptibility testing must be tailored to the patient’s age, immune status, and infection site. For pediatric populations, dosage adjustments are critical; for instance, the recommended ampicillin dose for neonates is 50–200 mg/kg/day, divided every 6–8 hours, compared to 50 mg/kg/day for older children. Additionally, clinicians should consider pharmacokinetic/pharmacodynamic (PK/PD) principles, such as using beta-lactams as time-dependent antibiotics (requiring prolonged drug exposure) versus aminoglycosides as concentration-dependent agents (requiring peak concentrations). By integrating these specifics, antibiotic susceptibility testing becomes a powerful tool for differentiating and treating non-spore-forming bacteria effectively.
Optimize Spore Performance: Proven Tips to Eliminate Lag Instantly
You may want to see also
Frequently asked questions
Non-spore forming bacteria are a group of bacteria that lack the ability to produce endospores, which are highly resistant structures used for survival in harsh conditions. Differentiating them is crucial because they are more susceptible to environmental stresses, disinfection, and antibiotics, making them important in clinical, food safety, and industrial contexts.
Key methods include spore staining (e.g., Schaeffer-Fulton stain), where non-spore formers will not show endospores under microscopy, and heat treatment, where non-spore formers are killed at high temperatures while spore-formers may survive. Additionally, biochemical tests and molecular techniques like PCR can identify specific genes absent in non-spore formers.
Yes, non-spore forming bacteria, such as *E. coli* and *Staphylococcus*, can cause infections and contamination. They are generally easier to control than spore-formers due to their lower resistance. Treatment typically involves antibiotics, proper hygiene, and disinfection methods tailored to their susceptibility.

























